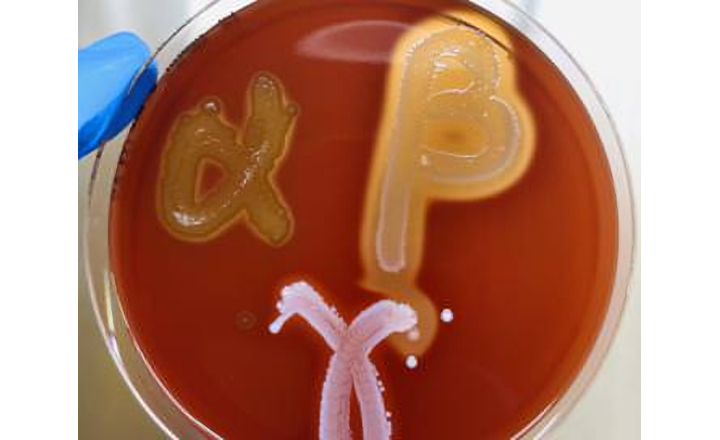
Clear Haeomolysis Results on Liofilchem Columbia Agar

Columbia Agar (Sheep blood 5%) is a medium used for the growth of fastidious and non-fastidious organisms and determination of haemolytic reactions as a basis for identification.
Interpretation of Haemolysis: Four different kinds of haemolysis can be observed
- Alpha haemolysis: Partial lysis of red blood cells (haemoglobin is reduced to metahaemoglobin), results in a greenish or brownish discoloration around the colonies in the medium surrounding the colony.
- Beta haemolysis: Complete lysis of red blood cells, resulting in a clear zone around the bacterial colonies. Examples of beta-haemolytic bacteria include Streptococcus pyogenes (Group A Streptococcus), Staphylococcus aureus, and Streptococcus agalactiae (Group B Streptococcus)
- Gamma haemolysis: No hemolysis, with no change in color of the medium around the colonies
- Alpha-prime haemolysis: a small zone of complete haemolysis is surrounded by an area of partial lysis.
























